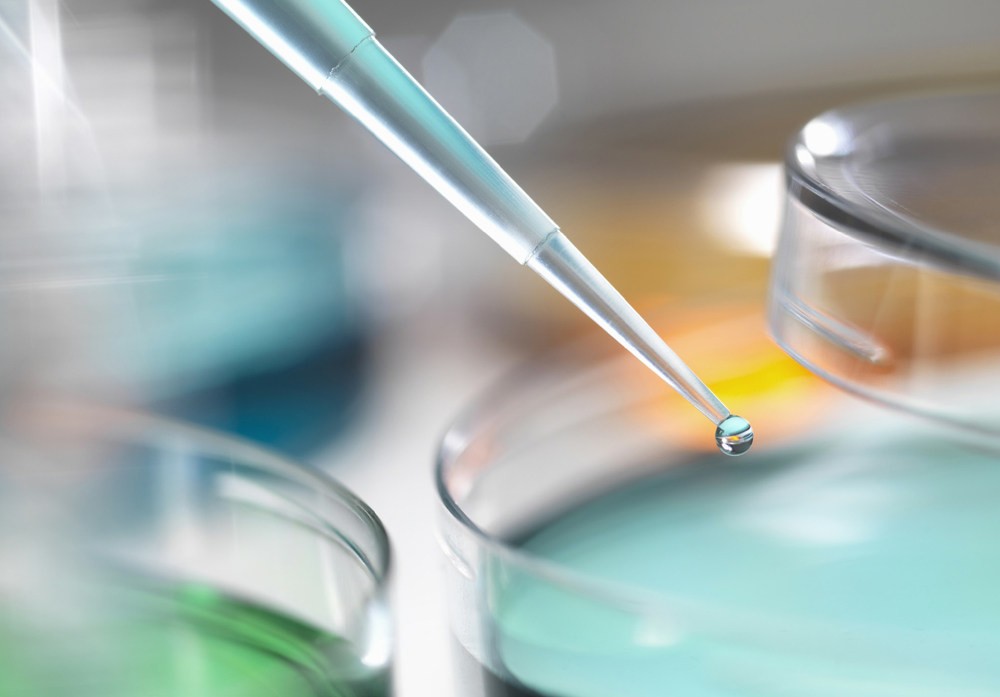
食品理化检验中样品前处理技术的应用及意义

理化检验

理化实验演示
图片尺寸900x1350
理化检验包括哪些项目—化学测试实验室【商通检测】
图片尺寸510x288
热烈祝贺我中心理化检验室被评为2014年全国供销合作社优秀质量管理
图片尺寸498x332
食品理化检验中样品前处理技术的应用及意义
图片尺寸1000x697
理化检验技术医学副高.#创作灵感 #理化检验技术 #理化检验 - 抖音
图片尺寸1440x1440
理化实验室
图片尺寸3968x2976
实验室理化实验
图片尺寸1978x1199
bk 食品理化检验(供卫生检验与检疫专业用第2版全国高等学校教材)
图片尺寸1280x1954
2018年中考理化生实验考核顺利完成
图片尺寸1269x1904
无穷食品的理化检验室.受访者供图
图片尺寸1375x909
小鼠肝脂酶hlelisa试剂盒
图片尺寸2000x1333
安徽植物提取物检测报告,出具cma/cnas,全球认可
图片尺寸500x325
浙江开展纸质吸管质量比较试验2批次样品高锰酸钾消耗量超标
图片尺寸1920x1080
农药理化检测
图片尺寸3216x2136
食品理化检验实验室建设规划方案
图片尺寸600x400
得瑞尔理化检验实验室-得瑞尔-高温润滑脂,粉末冶金轴承润滑,食品级
图片尺寸768x1120
2018年中考理化生实验考核顺利完成
图片尺寸1269x1904
湖北理化分析检测中心全员践行检测即责任理念
图片尺寸900x585
兰化一中新区校区新学期理化生实验室检查
图片尺寸2592x1728
文科理科图片
图片尺寸450x300